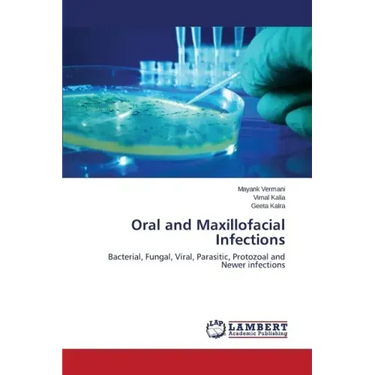

Oral and Maxillofacial Infections - Paperback
Oral and Maxillofacial Infections - Paperback
$126.59
/

products.product.pickup_availability.unavailable
Your payment information is processed securely. We do not store credit card details nor have access to your credit card information.
by Vermani Mayank (Author), Kalia Vimal (Author), Kalra Geeta (Author)
There have been many advances in the management of maxillofacial infections. New classes of antimicrobial agents, non-invasive imaging techniques, improved culturing methods, and clearer understandings of the normal and pathologic functioning of the immune system are just some of the changes that have occurred. These and other technological advances have enhanced dramatically our ability to diagnose and treat these infections rapidly and accurately. As a result, the incidence of serious morbidity and mortality from odontogenic infections has fallen significantly over the years. It should be noted, however, that vigilance regarding research and technologic changes must be maintained. Just as we have made many advances in the management of these infections, an equal number of new and serious issues have arisen to test our resolve. For every new drug we formulate, resistance develops to an older and often used one. For every organism that we eradicate, another one suddenly emerges to take its place. Therefore, thorough understanding of newer infections is required for the survival of mankind.